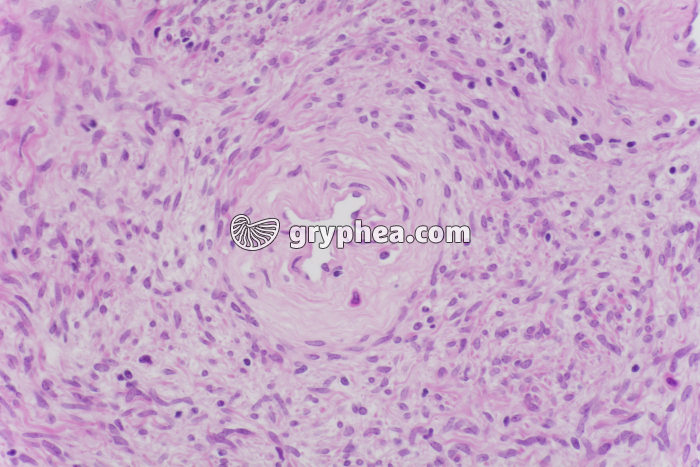
Prostate x100 - gryphea.com

Type : Photographie
Référence : BN 52164
Auteur : Hervé Conge
Edition et PresseNumérique et Internet
Valeur du crédit
1 crédit = 6.00€ TTC
(Hors pack)
1 crédit = 6.00€ TTC
(Hors pack)
si vous êtes enseignant, le site gryphea.org a été conçu spécialement pour vous !
Edition et Presse
Paramètres additionnels
Tirage
Distribution
Durée d'utilisation
Droits numériques en sus
Total : crédits
Ajouter au panier
Numérique et Internet
Paramètres additionnels
Numérique
Internet
Durée d'utilisation
Total : crédits
Ajouter au panier
Numérique et Internet
Paramètres additionnels
Numérique
Internet
Durée d'utilisation
Total : 4 crédits
Ajouter au panier
Légende :
La suite du commentaire est réservée aux inscrits, créez un compte gratuitement.
La prostate est un organe impair situé à la base de la vessie, dont les sécrétions nutritives se combinent aux sécrétions des 2 vésicules séminales et des glandes de Cowper, pour entrer dans la composition du sperme (liquide spermatique). Cet organe annexe de l’appareil reproducteur mâle des mammifères comporte quelques dizaines de glandes tubulo-alvéolaires, lui conférant une structure avec des cavités de forme irrégulière.
La suite du commentaire est réservée aux inscrits, créez un compte gratuitement.
Thèmes associés :
Système reproducteur